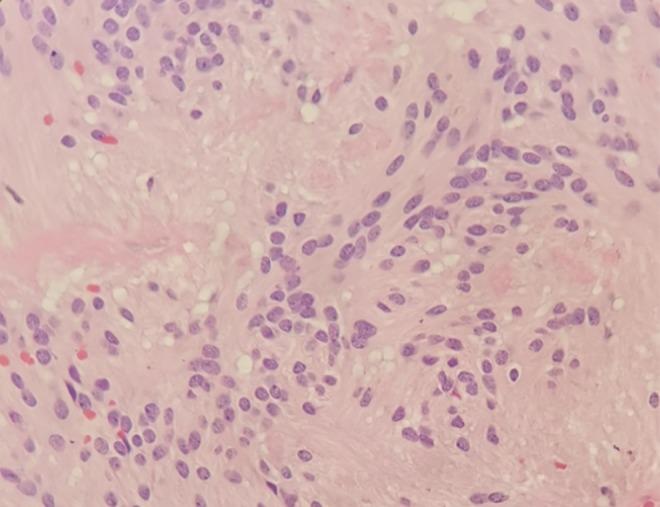
https://cdn.ncbi.nlm.nih.gov/pmc/blobs/ed40/7003710/b4e8f20903f4/AGM2-2-223-g002.jpg

Parkinsonism caused by Intracranial ependymoma: A rare case report and literature review.
作者信息
Lou Yue, Wang Yanwen, Zhuang Liying, Cai Miao, Liu Xiaoli
机构信息
Department of Neurology Zhejiang Hospital Hangzhou China.
出版信息
Aging Med (Milton). 2019 Dec 27;2(4):223-226. doi: 10.1002/agm2.12093. eCollection 2019 Dec.
BACKGROUND
Ependymomas, especially intracranial ependymomas, are rare neoplasms of the CNS. The clinical courses of patients with intracranial ependymomas can be quite variable. At present, data on parkinsonism caused by ependymomas are scarce.
CASE PRESENTATION
A 13-year-old girl presented with parkinsonism symptoms of clumsiness in her left leg and hand. Her mother was diagnosed with Parkinson's disease at age 30, nine years previously. Magnetic resonance imaging showed a lesion in the temporal lobe with long-T1 signal, mixed-T2 signal. The patient was taken in for a right tumorectomy and was diagnosed as having an ependymoma postoperatively. The patient's symptoms fully resolved in the postoperative phase.
CONCLUSION
The case describes the mechanism of intracranial ependymoma involving parkinsonism symptoms. Our findings suggest that in some patients presenting with atypical PD symptoms the underlying cause should not be overlooked; MRI examination is necessary.